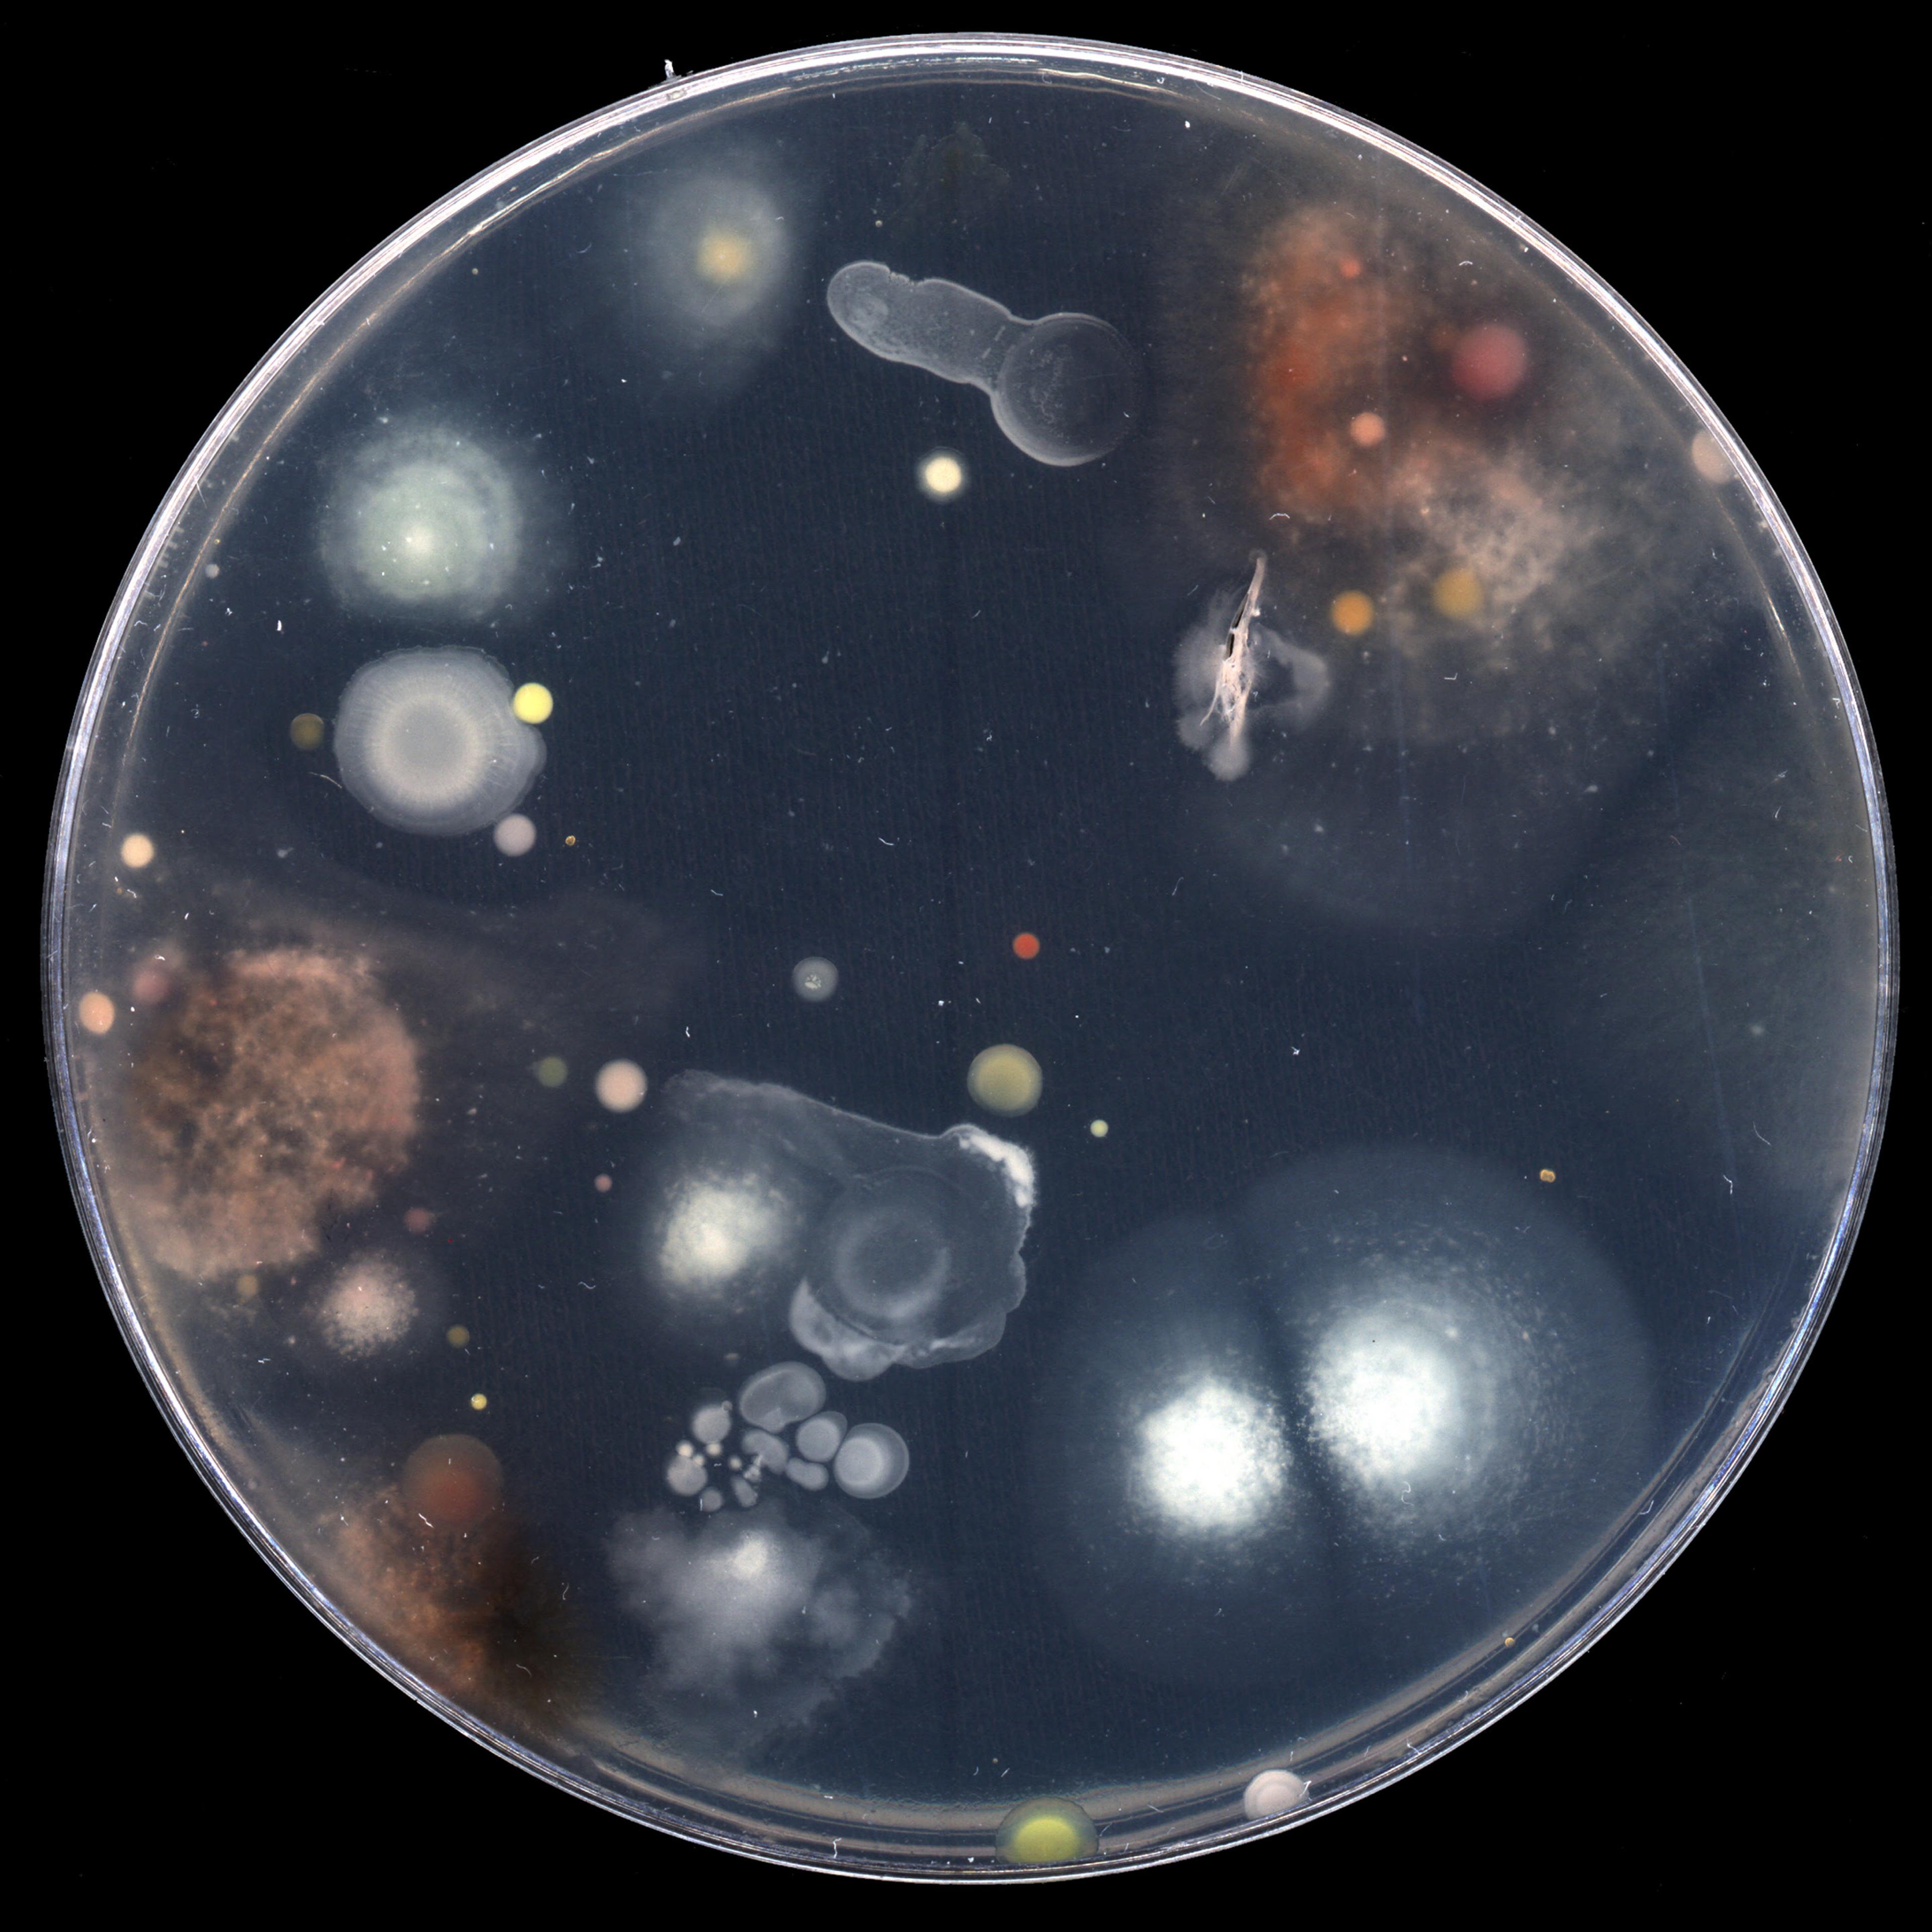
Dane Mitchell, Dust Archive, 2001– , glass, dust, plastic, board and foam. Installation view, Archiving Fever, Adam Art Gallery Te Pātaka Toi, Victoria University of Wellington, 2006

Group show
Archiving Fever
curated by Emily Cormack
03 August – 01 October 2006
Archiving Fever explored the role of memory and fiction in the way we understand and create archives. Spanning video, photography and installation, the works in the exhibition explored the human impulse to build narratives and connections to make sense of the world around us. The exhibition brought attention to the contemporary re-evaluation of the archive, placing an emphasis on the open-ended nature of raw archival material, and questioning how meaning is inscribed.
Patrick Pound and Ann Shelton’s photo-based works investigate the process of assigning meaning within an archive, focusing on the influence of personal or political viewpoints.
Similarly, Simon Denny and Heman Chong highlight this element of auteurship or biography in the archiving process, drawing on the matter of everyday life and arranging it according to personal systems of categorization.
Dane Mitchell collects and displays skin flakes and dust particles from museums, which he collates in a Dust Archive. These human traces record the history of the archive, and the way meaning is constructed within it.
Helmut Kandl’s work comprises 800 slides that were found in an abandoned house in Vienna. This work explores the parallels between the photographer and the archivist. It also reveals photography’s two-fold archival function, as both a system of framing and collation, and as open-ended archival material.
Further scrutinising the role of images within the archive, Gaston Ramirez Feltrin questions the authority of the moving image as an archival object. His video work reveals the extent to which the advent of computer games and digital camera’s has affected the authenticity of the moving image as a record.
Similarly, Popular Productions draws attention to the content in the archive. Their work plays with our perceptions of the archival image, editing 16mm, Super 8 and found footage together, revealing slippages in meaning that occur through juxtaposition.

Simon Denny, Arranging Sympathies, 2005-06, mixed media, dimension variable. Installation view, Archiving Fever, Adam Art Gallery Te Pātaka Toi, Victoria University of Wellington, 2006

Installation view, Archiving Fever, Adam Art Gallery Te Pātaka Toi, Victoria University of Wellington, 2006

Installation view, Archiving Fever, Adam Art Gallery Te Pātaka Toi, Victoria University of Wellington, 2006
Dane Mitchell, Dust Archive, 2001– , glass, dust, plastic, board and foam. Installation view, Archiving Fever, Adam Art Gallery Te Pātaka Toi, Victoria University of Wellington, 2006

Installation view, Archiving Fever, Adam Art Gallery Te Pātaka Toi, Victoria University of Wellington, 2006

Installation view, Archiving Fever, Adam Art Gallery Te Pātaka Toi, Victoria University of Wellington, 2006